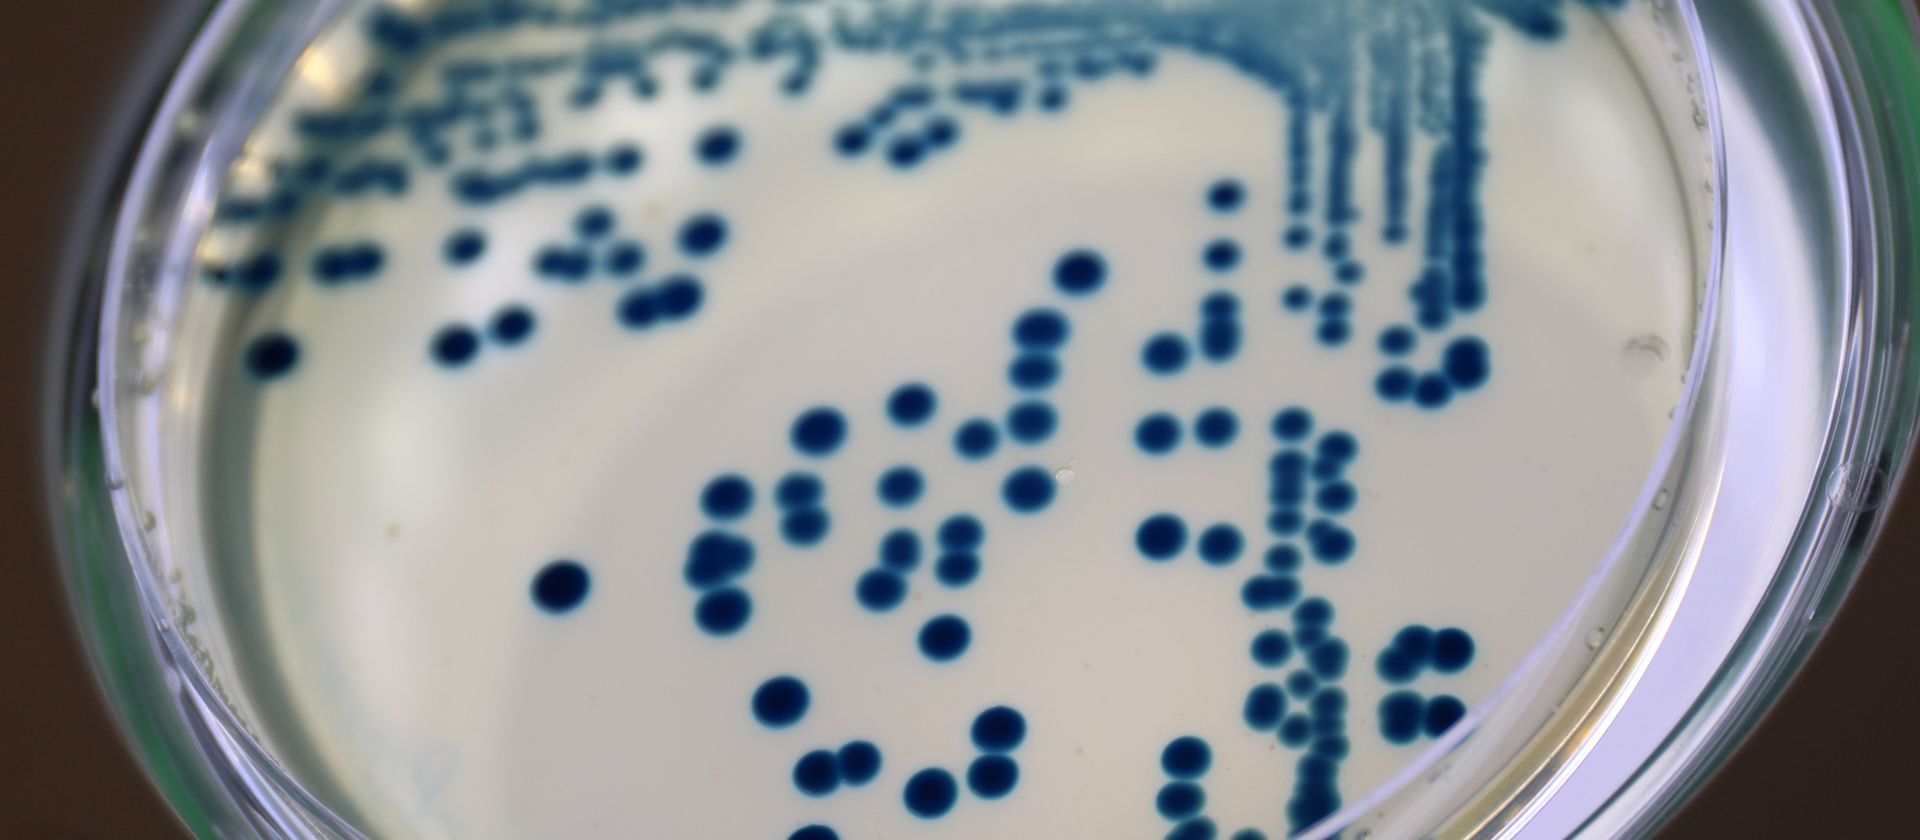

Antibiotikaresistenzen gehören zu den größten Herausforderungen für die globale Gesundheit. Forschende der Abteilung „Epidemiologie und Ökologie antimikrobieller Resistenz“ des HIOH unter der Leitung von Prof. Dr. Katharina Schaufler, PhD, haben nun mit Hilfe der funktionell-genomischen Methode TraDIS (Transposon-directed insertion-site sequencing) einen bislang verborgenen Zusammenhang zwischen Antibiotikaresistenz und Virulenz in Klebsiella pneumoniae aufgedeckt. Virulenz beschreibt dabei das Ausmaß, in dem ein Erreger Krankheiten auslösen kann. Die Ergebnisse wurden in der internationalen Fachzeitschrift Clinical Microbiology and Infection veröffentlicht.
AMR: ein globales Gesundheitsproblem
Klebsiella pneumoniae zählt zu den weltweit bedeutendsten Erregern schwerer Infektionen, insbesondere im medizinischen Umfeld (sogenannte nosokomiale Infektionen). Im Sinne des One Health-Ansatzes spielt das Bakterium eine wichtige Rolle, da es sowohl in der Umwelt vorkommt als auch bei Menschen und Tieren Infektionen auslösen kann. Besonders problematisch sind Stämme, die gegen viele Antibiotika resistent sind. In solchen Fällen verbleiben nur noch wenige Therapieoptionen.
Das Reserveantibiotikum Cefiderocol gilt als vielversprechende Behandlungsoption gegen diese resistenten Bakterien. Es wirkt wie ein „Trojanisches Pferd“, indem es sich als für die Bakterien lebenswichtiges Eisen „tarnt“, in die Zelle eingeschleust wird und die Bakterien abtötet. In den letzten Jahren wurde jedoch zunehmend berichtet, dass inzwischen selbst gegen Cefiderocol Resistenzen auftreten.